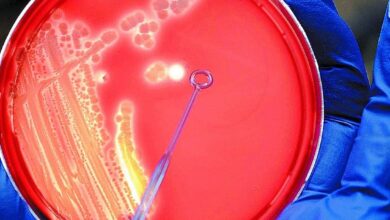

Día: 1 de noviembre de 2023
-
Mundo

La frontera con Gaza se abre por primera vez en semanas y algunos heridos ya llegan a Egipto
El cruce de Rafah desde Gaza a Egipto se ha abierto por primera vez desde que comenzó el asedio de…
Leer más » -
Locales

la experiencia gastronómica de 14 pasos y un homenaje a la historia del vino
Catorce copas vacías de diferentes tamaños reposan sobre un individual con una línea de tiempo impresa. El restaurante completamente vidriado…
Leer más » -
Locales

A pesar de que en el interior sigue faltando nafta, Sergio Massa aseguró que «la situación crítica se ha superado»
Aunque todavía se registran faltantes de combustible en algunas estaciones de servicio, el candidato presidencial de Unión por la Patria,…
Leer más » -
Mundo

El canciller de EE.UU. regresa con urgencia a Israel en medio de la escalada de la guerra y el desastre humanitario
El parte de guerra de este miércoles describe otra vez la Franja de Gaza incomunicada como sucedió el viernes último…
Leer más » -
Locales
cómo es el plan contrarreloj para frenar a las superbacterias
El progreso del ser humano contiene en sí mismo el germen de su posible destrucción. La frase apocalíptica propone un…
Leer más » -
Locales

El terror más espeluznante
Pocos autores como Stephen King han diseñado nuestras peores pesadillas. Algún recuerdo bien rojo de Carrie, un poco de It,…
Leer más » -
Locales

Pospusieron el aumento de impuestos que inciden en el precio de los combustibles
En medio de la escasez y desabastecimiento en las estaciones de servicio de todo el país, el Gobierno pospuso este…
Leer más » -
Locales

«Se separó un mes después de las elecciones»
Luego de que María Eugenia Vidal definiera a Sergio Massa como kirchnerista, Malena Galmarini, titular de AySA y esposa del…
Leer más » -
Locales

Declaran Monumento Histórico al boliche «República Cromañón» donde murieron 194 personas
El boliche «República Cromañón«, donde el 30 de diciembre de 2004 murieron 194 personas debido a un incendio durante un…
Leer más » -
Mundo

Carlos III emprende su primer viaje a Kenia como rey en medio de reclamos por un sangriento pasado colonial británico
El rey Carlos III y la reina Camilla emprendieron uno de los primeros viajes más estratégicos de su flamante reinado.…
Leer más »
